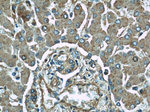
ME1 Antibody in Immunohistochemistry (Paraffin) (IHC (P))

Search
Proteintech
ME1 Polyclonal Antibody
{{$productOrderCtrl.translations['antibody.pdp.commerceCard.promotion.promotions']}}
{{$productOrderCtrl.translations['antibody.pdp.commerceCard.promotion.viewpromo']}}
{{$productOrderCtrl.translations['antibody.pdp.commerceCard.promotion.promocode']}}: {{promo.promoCode}} {{promo.promoTitle}} {{promo.promoDescription}}. {{$productOrderCtrl.translations['antibody.pdp.commerceCard.promotion.learnmore']}}
产品信息
16619-1-AP
种属反应
已发表种属
宿主/亚型
分类
类型
抗原
偶联物
形式
浓度
规格
纯化类型
保存液
内含物
保存条件
运输条件
产品详细信息
Immunogen sequence: DEFMEAVSS KYGMNCLIQF EDFANVNAFR LLNKYRNQYC TFNDDIQGTA SVAVAGLLAA LRITKNKLSD QTILFQGAGE AALGIAHLIV MALEKEGLPK EKAIKKIWLV DSKGLIVKGR ASLTQEKEKF AHEHEEMKNL EAIVQEIKPT ALIGVAAIGG AFSEQILKDM AAFNERPIIF ALSNPTSKAE CSAEQCYKIT KGRAIFASGS PFDPVTLPNG QTLYPGQGNN SYVFPGVALG VVACGLRQIT DNIFLTTAEV IAQQVSDKHL EEGRLYPPLN TIRDVSLKIA EKIVKDAYQE KTATVYPEPQ NKEAFVRSQM YSTDYDQILP DCYSWPEEVQ KIQTKVDQ (226-572 aa encoded by BC025246)
靶标信息
ME1 encodes a cytosolic, NADP-dependent enzyme that generates NADPH for fatty acid biosynthesis. The activity of this enzyme, the reversible oxidative decarboxylation of malate, links the glycolytic and citric acid cycles. The regulation of expression for this gene is complex. Increased expression can result from elevated levels of thyroid hormones or by higher proportions of carbohydrates in the diet.
仅用于科研。不用于诊断过程。未经明确授权不得转售。
生物信息学
蛋白别名: cytosolic malic enzyme 1; malate dehydrogenase (oxaloacetate-decarboxylating) (NADP(+)); malate dehydrogenase (oxaloacetate-decarboxylating) (NADP+); Malic enzyme 1; malic enzyme 1, NADP(+)-dependent, cytosolic; malic enzyme 1, soluble; Malic enzyme, cytoplasmic; malic enzyme, supernatant; NADP-dependent malic enzyme; NADP-ME; pyruvic-malic carboxylase; unnamed protein product
基因别名: D9Ertd267e; HUMNDME; Mdh-1; ME1; MES; Mod-1; MOD1
UniProt ID: (Human) P48163, (Mouse) P06801
Entrez Gene ID: (Human) 4199, (Mouse) 17436, (Rat) 24552